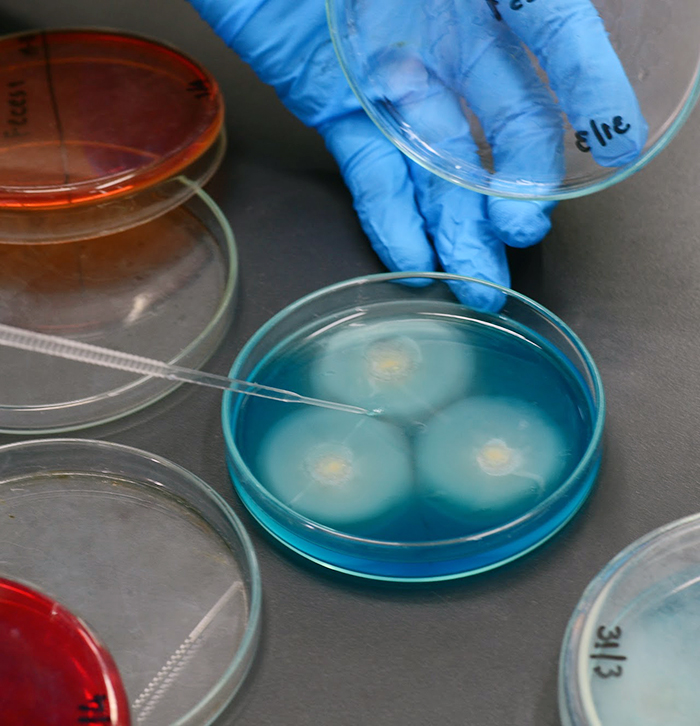

กลุ่มแบคทีเรียและเชื้อรา (Bateriology and Mycology Section)
- ศึกษา ค้นคว้า วิจัยเกี่ยวกับแบคทีเรียและเชื้อรา และพัฒนาเทคนิคการตรวจวินิจฉัย และชันสูตรโรคด้านแบคทีเรียและเชื้อรา เพื่อให้มีประสิทธิภาพและได้มาตรฐานสากล
- เป็นห้องปฏิบัติการอ้างอิง ดำเนินการตรวจวินิจฉัยและชันสูตรโรคทางแบคทีเรียและเชื้อรา
- ศึกษา ค้นคว้า วิจัย และพัฒนาการผลิตชีวสาร สารทดสอบ และวัคซีนต้นแบบทางแบคทีเรียและเชื้อรา
- ศึกษา วิจัยด้านชีวโมเลกุลของแบคทีเรียและเชื้อรา - ศึกษาความไวของเชื้อต่อยาต้านจุลชีพเพื่อการรักษาและเฝ้าระวังเชื้อดื้อยา
- อนุรักษ์ ศึกษา และใช้ประโยชน์ความหลากหลายทางชีวภาพของสายพันธุ์แบคทีเรียและเชื้อรา
- ให้คำปรึกษา แนะนำ และถ่ายทอดเทคโนโลยีในการตรวจวินิจฉัยและชันสูตรโรคสัตว์ทางแบคทีเรียและเชื้อรา

บริการตรวจวินิจฉัยเชื้อแบคทีเรียและเชื้อราก่อโรค
- Detection
- Identification
- Antimicrobial Susceptibility Testt

บริการตรวจเชื้อก่อโรคในจิ้งหรีด
- Cricket Paralysis Virus (CrPV)
- Iridovirus
- Pathogenic bacteria

โครงการเฝ้าระวังเชื้อดื้อยา National AMR Surveillance Project
- Escherichia coli
- Campylobacter jejuni/coli
- Enterococcus faecalis/faecium
- Salmonella spp.

กระทรวงเกษตรและสหกรณ์
กรมปศุสัตว์